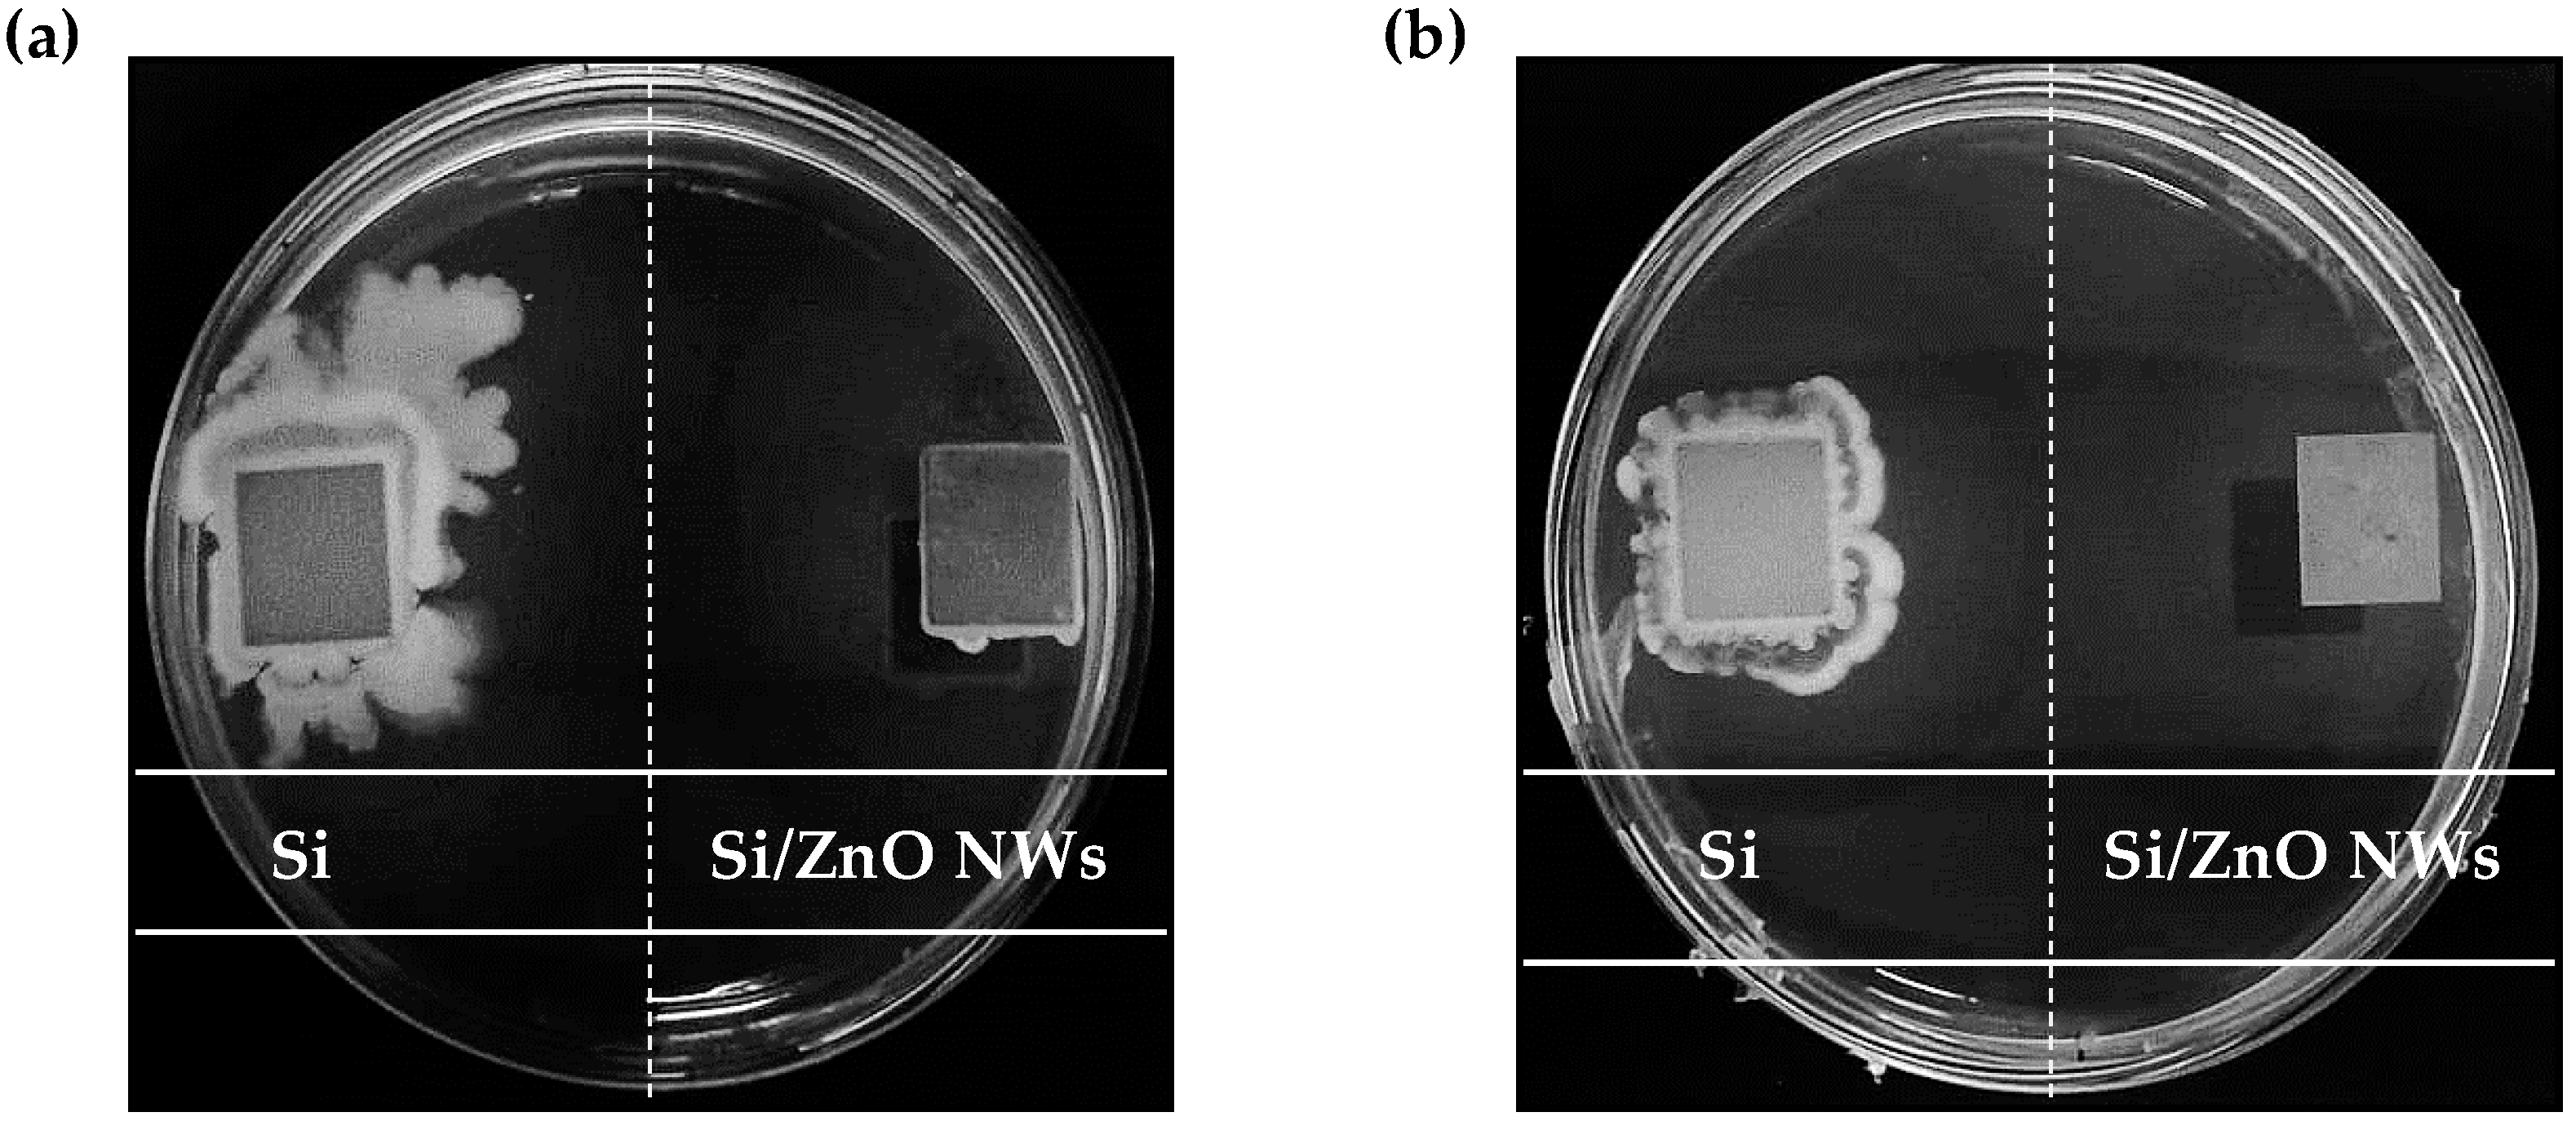
Coatings 14 00041 g007

Antibacterial and Photocatalytic Properties of ZnO Nanostructure Decorated Coatings
Abstract
:1. Introduction
2. Materials and Methods
2.1. Materials
2.2. Synthesis of ZnO Nanowires
2.3. Photocatalytic Activity Evaluation
2.4. Antibacterial Activity Evaluation: Growth Conditions, Sample Preparation, and Tests
- Serial Dilution: First, 100 µL of the overnight-grown culture of P. putida was diluted in 900 µL of sterile potassium chloride (KCl, 9 g/L) solution, resulting in a 1:10 dilution (referred to as a 101 dilution). This dilution process was repeated seven more times, resulting in 102 to 108 dilutions of M2′.
- Plating on LB agar: 100 µL of each dilution was evenly distributed on LB agar using a sterile spreader, under a laminar flow hood. The Petri dishes were then incubated overnight.
- Colony Observation: After overnight incubation, the bacterial colonies were macroscopically observed. The number of CFUs was assumed to be equivalent to the number of live cells in suspension [58].
- CFU/mL Calculation: The colonies were counted and were used to calculate the CFU/mL (x) in the bacterial suspension (M2′) with the help of the following equation,
- Under a laminar flow hood, both the Si substrate and Si/ZnO NW sample underwent a 30 min UV light disinfection procedure to ensure the surfaces were aseptic.
- 100 µL of the P. putida culture (M2′; 4.1 × 107 CFU/mL) was dropped both onto the substrate and sample surfaces.
- Both substrates were either left in the dark or exposed to UV light at an intensity of 0.17 W/cm2 for 10 min. This step allowed us to assess the impact of UV light on the antibacterial activity of ZnO NWs and gain an insight into the generation of ROS.
- The substrates were air-dried for approximately 2 h under the laminar flow hood to allow bacterial adhesion to the surfaces and media evaporation.
- The inoculated surfaces of the Si and Si/ZnO NWs were gently pressed onto LB agar contained in Petri dishes. This step allowed the transfer of bacterial cells initially deposed on the substrates onto the growth medium.
- The Petri dishes were placed in an incubator set at 31 °C and allowed to incubate for 24 h, providing optimal conditions for the growth of viable P. putida bacterial cells remaining after being in contact with the samples with or without UV light exposure.
2.5. Characterization Techniques
3. Results
3.1. Unveiling the Morphology and Optical Properties of Prepared ZnO NWs
3.2. Unveiling the Photocatalytic and Antibacterial Properties of Prepared ZnO Nanowires
4. Discussion
5. Conclusions
Author Contributions
Funding
Institutional Review Board Statement
Informed Consent Statement
Data Availability Statement
Conflicts of Interest
References
- Boucher, H.W.; Talbot, G.H.; Bradley, J.S.; Edwards, J.E.; Gilbert, D.; Rice, L.B.; Scheld, M.; Spellberg, B.; Bartlett, J. Bad Bugs, No Drugs: No ESKAPE! An Update from the Infectious Diseases Society of America. Clin. Infect. Dis. 2009, 48, 1–12. [Google Scholar] [CrossRef] [PubMed]
- Levy, S.B.; Marshall, B. Antibacterial Resistance Worldwide: Causes, Challenges and Responses. Nat. Med. 2004, 10, S122–S129. [Google Scholar] [CrossRef] [PubMed]
- Spellberg, B.; Guidos, R.; Gilbert, D.; Bradley, J.; Boucher, H.W.; Scheld, W.M.; Bartlett, J.G.; Edwards, J., Jr.; Infectious Diseases Society of America. The Epidemic of Antibiotic-Resistant Infections: A Call to Action for the Medical Community from the Infectious Diseases Society of America. Clin. Infect. Dis. 2008, 46, 155–164. [Google Scholar] [CrossRef] [PubMed]
- Rodvold, K.A.; McConeghy, K.W. Methicillin-Resistant Staphylococcus Aureus Therapy: Past, Present, and Future. Clin. Infect. Dis. Off. Publ. Infect. Dis. Soc. Am. 2014, 58 (Suppl. S1), S20–S27. [Google Scholar] [CrossRef] [PubMed]
- O’Neill, J. Tackling Drug-Resistant Infections Globally: Final Report and Recommendations; Government of the United Kingdom: London, UK, 2016. [Google Scholar]
- Knetsch, M.L.W.; Koole, L.H. New Strategies in the Development of Antimicrobial Coatings: The Example of Increasing Usage of Silver and Silver Nanoparticles. Polymers 2011, 3, 340–366. [Google Scholar] [CrossRef]
- Ivanova, E.P.; Hasan, J.; Truong, V.K.; Wang, J.Y.; Raveggi, M.; Fluke, C.; Crawford, R.J. The Influence of Nanoscopically Thin Silver Films on Bacterial Viability and Attachment. Appl. Microbiol. Biotechnol. 2011, 91, 1149–1157. [Google Scholar] [CrossRef] [PubMed]
- Ivanova, E.P.; Truong, V.K.; Webb, H.K.; Baulin, V.A.; Wang, J.Y.; Mohammodi, N.; Wang, F.; Fluke, C.; Crawford, R.J. Differential Attraction and Repulsion of Staphylococcus Aureus and Pseudomonas Aeruginosa on Molecularly Smooth Titanium Films. Sci. Rep. 2011, 1, 165. [Google Scholar] [CrossRef] [PubMed]
- Menéndez Miranda, M.; Liu, W.; Godinez-Leon, J.A.; Amanova, A.; Houel-Renault, L.; Lampre, I.; Remita, H.; Gref, R. Colloidal Silver Nanoparticles Obtained via Radiolysis: Synthesis Optimization and Antibacterial Properties. Pharmaceutics 2023, 15, 1787. [Google Scholar] [CrossRef] [PubMed]
- Kälicke, T.; Schierholz, J.; Schlegel, U.; Frangen, T.M.; Köller, M.; Printzen, G.; Seybold, D.; Klöckner, S.; Muhr, G.; Arens, S. Effect on Infection Resistance of a Local Antiseptic and Antibiotic Coating on Osteosynthesis Implants: An in Vitro and in Vivo Study. J. Orthop. Res. Off. Publ. Orthop. Res. Soc. 2006, 24, 1622–1640. [Google Scholar] [CrossRef] [PubMed]
- Banerjee, I.; Pangule, R.C.; Kane, R.S. Antifouling Coatings: Recent Developments in the Design of Surfaces That Prevent Fouling by Proteins, Bacteria, and Marine Organisms. Adv. Mater. 2011, 23, 690–718. [Google Scholar] [CrossRef] [PubMed]
- Nederberg, F.; Zhang, Y.; Tan, J.P.K.; Xu, K.; Wang, H.; Yang, C.; Gao, S.; Guo, X.D.; Fukushima, K.; Li, L.; et al. Biodegradable Nanostructures with Selective Lysis of Microbial Membranes. Nat. Chem. 2011, 3, 409–414. [Google Scholar] [CrossRef] [PubMed]
- Elbourne, A.; Chapman, J.; Gelmi, A.; Cozzolino, D.; Crawford, R.J.; Truong, V.K. Bacterial-Nanostructure Interactions: The Role of Cell Elasticity and Adhesion Forces. J. Colloid Interface Sci. 2019, 546, 192–210. [Google Scholar] [CrossRef] [PubMed]
- Elbourne, A.; Truong, V.K.; Cheeseman, S.; Rajapaksha, P.; Gangadoo, S.; Chapman, J.; Crawford, R. The Use of Nanomaterials for the Mitigation of Pathogenic Biofilm Formation. Methods Microbiol. 2019, 46, 61–92. [Google Scholar] [CrossRef]
- Bridier, A.; Briandet, R.; Thomas, V.; Dubois-Brissonnet, F. Resistance of Bacterial Biofilms to Disinfectants: A Review. Biofouling 2011, 27, 1017–1032. [Google Scholar] [CrossRef]
- Johnston, H.J.; Hutchison, G.; Christensen, F.M.; Peters, S.; Hankin, S.; Stone, V. A Review of the in Vivo and in Vitro Toxicity of Silver and Gold Particulates: Particle Attributes and Biological Mechanisms Responsible for the Observed Toxicity. Crit. Rev. Toxicol. 2010, 40, 328–346. [Google Scholar] [CrossRef] [PubMed]
- Stigter, M.; Bezemer, J.; de Groot, K.; Layrolle, P. Incorporation of Different Antibiotics into Carbonated Hydroxyapatite Coatings on Titanium Implants, Release and Antibiotic Efficacy. J. Control. Release Off. J. Control. Release Soc. 2004, 99, 127–137. [Google Scholar] [CrossRef] [PubMed]
- Jang, Y.; Choi, W.T.; Johnson, C.T.; García, A.J.; Singh, P.M.; Breedveld, V.; Hess, D.W.; Champion, J.A. Inhibition of Bacterial Adhesion on Nanotextured Stainless Steel 316L by Electrochemical Etching. ACS Biomater. Sci. Eng. 2018, 4, 90–97. [Google Scholar] [CrossRef] [PubMed]
- Onaizi, S.A.; Leong, S.S.J. Tethering Antimicrobial Peptides: Current Status and Potential Challenges. Biotechnol. Adv. 2011, 29, 67–74. [Google Scholar] [CrossRef] [PubMed]
- Pogodin, S.; Hasan, J.; Baulin, V.A.; Webb, H.K.; Truong, V.K.; Phong Nguyen, T.H.; Boshkovikj, V.; Fluke, C.J.; Watson, G.S.; Watson, J.A.; et al. Biophysical Model of Bacterial Cell Interactions with Nanopatterned Cicada Wing Surfaces. Biophys. J. 2013, 104, 835–840. [Google Scholar] [CrossRef] [PubMed]
- Ivanova, E.P.; Hasan, J.; Webb, H.K.; Truong, V.K.; Watson, G.S.; Watson, J.A.; Baulin, V.A.; Pogodin, S.; Wang, J.Y.; Tobin, M.J.; et al. Natural Bactericidal Surfaces: Mechanical Rupture of Pseudomonas Aeruginosa Cells by Cicada Wings. Small 2012, 8, 2489–2494. [Google Scholar] [CrossRef] [PubMed]
- Tripathy, A.; Sen, P.; Su, B.; Briscoe, W.H. Natural and Bioinspired Nanostructured Bactericidal Surfaces. Adv. Colloid Interface Sci. 2017, 248, 85–104. [Google Scholar] [CrossRef] [PubMed]
- Elbourne, A.; Crawford, R.J.; Ivanova, E.P. Nano-Structured Antimicrobial Surfaces: From Nature to Synthetic Analogues. J. Colloid Interface Sci. 2017, 508, 603–616. [Google Scholar] [CrossRef] [PubMed]
- Luong-Van, E.; Rodriguez, I.; Low, H.Y.; Elmouelhi, N.; Lowenhaupt, B.; Natarajan, S.; Lim, C.T.; Prajapati, R.; Vyakarnam, M.; Cooper, K. Review: Micro- and Nanostructured Surface Engineering for Biomedical Applications. J. Mater. Res. 2013, 28, 165–174. [Google Scholar] [CrossRef]
- Linklater, D.P.; Juodkazis, S.; Ivanova, E.P. Nanofabrication of Mechano-Bactericidal Surfaces. Nanoscale 2017, 9, 16564–16585. [Google Scholar] [CrossRef] [PubMed]
- Li, X. Bactericidal Mechanism of Nanopatterned Surfaces. Phys. Chem. Chem. Phys. 2016, 18, 1311–1316. [Google Scholar] [CrossRef] [PubMed]
- Nguyen, K.N.; Basset, P.; Marty, F.; Leprince-Wang, Y.; Bourouina, T. On the Optical and Morphological Properties of Microstructured Black Silicon Obtained by Cryogenic-Enhanced Plasma Reactive Ion Etching. J. Appl. Phys. 2013, 113, 194903. [Google Scholar] [CrossRef]
- Ivanova, E.P.; Hasan, J.; Webb, H.K.; Gervinskas, G.; Juodkazis, S.; Truong, V.K.; Wu, A.H.F.; Lamb, R.N.; Baulin, V.A.; Watson, G.S.; et al. Bactericidal Activity of Black Silicon. Nat. Commun. 2013, 4, 2838. [Google Scholar] [CrossRef]
- Arias, A.C.; MacKenzie, J.D.; McCulloch, I.; Rivnay, J.; Salleo, A. Materials and Applications for Large Area Electronics: Solution-Based Approaches. Chem. Rev. 2010, 110, 3–24. [Google Scholar] [CrossRef] [PubMed]
- Diodati, S.; Dolcet, P.; Casarin, M.; Gross, S. Pursuing the Crystallization of Mono- and Polymetallic Nanosized Crystalline Inorganic Compounds by Low-Temperature Wet-Chemistry and Colloidal Routes. Chem. Rev. 2015, 115, 11449–11502. [Google Scholar] [CrossRef] [PubMed]
- Zhang, J. Silver-Coated Zinc Oxide Nanoantibacterial Synthesis and Antibacterial Activity Characterization. In Proceedings of the ICEOE 2011—2011 International Conference on Electronics and Optoelectronics, Dalian, China, 29–31 July 2011; Volume 3. [Google Scholar] [CrossRef]
- Firouzabadi, F.B.; Noori, M.; Edalatpanah, Y.; Mirhosseini, M. ZnO Nanoparticle Suspensions Containing Citric Acid as Antimicrobial to Control Listeria Monocytogenes, Escherichia Coli, Staphylococcus Aureus and Bacillus Cereus in Mango Juice. Food Control 2014, 42, 310–314. [Google Scholar] [CrossRef]
- Ruffolo, S.A.; La Russa, M.F.; Malagodi, M.; Oliviero Rossi, C.; Palermo, A.M.; Crisci, G.M. ZnO and ZnTiO3 Nanopowders for Antimicrobial Stone Coating. Appl. Phys. A 2010, 100, 829–834. [Google Scholar] [CrossRef]
- Butcher, P.N.; March, N.H.; Tosi, M.P. (Eds.) Crystalline Semiconducting Materials and Devices, 1st ed.; Springer: New York, NY, USA, 1986; ISBN 9781475799026. [Google Scholar]
- Petkov, P.; Tsiulyanu, D.; Popov, C.; Kulisch, W. Nanoscience Advances in CBRN Agent Detection, Information and Energy Security: An Introduction; Springer: Dordrecht, The Netherlands, 2015; pp. 3–13. [Google Scholar]
- Gomez, J.L.; Tigli, O. Zinc Oxide Nanostructures: From Growth to Application. J. Mater. Sci. 2013, 48, 612–624. [Google Scholar] [CrossRef]
- Wang, Z.L. Zinc Oxide Nanostructures: Growth, Properties and Applications. J. Phys. Condens. Matter 2004, 16, R829. [Google Scholar] [CrossRef]
- Schmidt-Mende, L.; MacManus-Driscoll, J.L. ZnO—Nanostructures, Defects, and Devices. Mater. Today 2007, 10, 40–48. [Google Scholar] [CrossRef]
- Özgür, Ü.; Alivov, Y.I.; Liu, C.; Teke, A.; Reshchikov, M.A.; Doğan, S.; Avrutin, V.; Cho, S.-J.; Morkoç, H. A Comprehensive Review of ZnO Materials and Devices. J. Appl. Phys. 2005, 98, 41301. [Google Scholar] [CrossRef]
- Le Pivert, M.; Kerivel, O.; Zerelli, B.; Leprince-Wang, Y. ZnO Nanostructures Based Innovative Photocatalytic Road for Air Purification. J. Clean. Prod. 2021, 318, 128447. [Google Scholar] [CrossRef]
- Le Pivert, M.; Martin, N.; Leprince-Wang, Y. Hydrothermally Grown ZnO Nanostructures for Water Purification via Photocatalysis. Crystals 2022, 12, 308. [Google Scholar] [CrossRef]
- Petersen, E.W.; Likovich, E.M.; Russell, K.J.; Narayanamurti, V. Growth of ZnO Nanowires Catalyzed by Size-Dependent Melting of Au Nanoparticles. Nanotechnology 2009, 20, 405603. [Google Scholar] [CrossRef] [PubMed]
- Lim, S.K.; Hwang, S.H.; Kim, S. Microemulsion Synthesis and Characterization of Aluminum Doped ZnO Nanorods. Cryst. Res. Technol. 2010, 45, 771–775. [Google Scholar] [CrossRef]
- Protasova, L.N.; Rebrov, E.V.; Choy, K.L.; Pung, S.Y.; Engels, V.; Cabaj, M.; Wheatley, A.E.H.; Schouten, J.C. ZnO Based Nanowires Grown by Chemical Vapour Deposition for Selective Hydrogenation of Acetylene Alcohols. Catal. Sci. Technol. 2011, 1, 768–777. [Google Scholar] [CrossRef]
- Cheng, H.-M.; Chiu, W.-H.; Lee, C.-H.; Tsai, S.-Y.; Hsieh, W.-F. Formation of Branched ZnO Nanowires from Solvothermal Method and Dye-Sensitized Solar Cells Applications. J. Phys. Chem. C 2008, 112, 16359–16364. [Google Scholar] [CrossRef]
- Hu, H.; Huang, X.; Deng, C.; Chen, X.; Qian, Y. Hydrothermal Synthesis of ZnO Nanowires and Nanobelts on a Large Scale. Mater. Chem. Phys. 2007, 106, 58–62. [Google Scholar] [CrossRef]
- Chevalier-César, C.; Capochichi-Gnambodoe, M.; Leprince-Wang, Y. Growth Mechanism Studies of ZnO Nanowire Arrays via Hydrothermal Method. Appl. Phys. A 2014, 115, 953–960. [Google Scholar] [CrossRef]
- Sirelkhatim, A.; Mahmud, S.; Seeni, A.; Kaus, N.H.M.; Ann, L.C.; Bakhori, S.K.M.; Hasan, H.; Mohamad, D. Review on Zinc Oxide Nanoparticles: Antibacterial Activity and Toxicity Mechanism. Nano-Micro Lett. 2015, 7, 219–242. [Google Scholar] [CrossRef] [PubMed]
- Brayner, R.; Ferrari-Iliou, R.; Brivois, N.; Djediat, S.; Benedetti, M.F.; Fiévet, F. Toxicological Impact Studies Based on Escherichia Coli Bacteria in Ultrafine ZnO Nanoparticles Colloidal Medium. Nano Lett. 2006, 6, 866–870. [Google Scholar] [CrossRef] [PubMed]
- Yamamoto, O.; Komatsu, M.; Sawai, J.; Nakagawa, Z.-E. Effect of Lattice Constant of Zinc Oxide on Antibacterial Characteristics. J. Mater. Sci. Mater. Med. 2004, 15, 847–851. [Google Scholar] [CrossRef]
- Lipovsky, A.; Nitzan, Y.; Gedanken, A.; Lubart, R. Antifungal Activity of ZnO Nanoparticles—The Role of ROS Mediated Cell Injury. Nanotechnology 2011, 22, 105101. [Google Scholar] [CrossRef] [PubMed]
- Dwivedi, S.; Wahab, R.; Khan, F.; Mishra, Y.K.; Musarrat, J.; Al-Khedhairy, A.A. Reactive Oxygen Species Mediated Bacterial Biofilm Inhibition via Zinc Oxide Nanoparticles and Their Statistical Determination. PLoS ONE 2014, 9, e111289. [Google Scholar] [CrossRef] [PubMed]
- Lakshmi Prasanna, V.; Vijayaraghavan, R. Insight into the Mechanism of Antibacterial Activity of ZnO: Surface Defects Mediated Reactive Oxygen Species Even in the Dark. Langmuir 2015, 31, 9155–9162. [Google Scholar] [CrossRef] [PubMed]
- Shimada, T.; Yasui, T.; Yonese, A.; Yanagida, T.; Kaji, N.; Kanai, M.; Nagashima, K.; Kawai, T.; Baba, Y. Mechanical Rupture-Based Antibacterial and Cell-Compatible ZnO/SiO2 Nanowire Structures Formed by Bottom-Up Approaches. Micromachines 2020, 11, 610. [Google Scholar] [CrossRef] [PubMed]
- Martin, N.; Leprince-Wang, Y. HPLC-MS and UV–Visible Coupled Analysis of Methylene Blue Photodegradation by Hydrothermally Grown ZnO Nanowires. Phys. Status Solidi 2021, 218, 2100532. [Google Scholar] [CrossRef]
- Habba, Y.G.; Capochichi-Gnambodoe, M.; Serairi, L.; Leprince-Wang, Y. Enhanced Photocatalytic Activity of ZnO Nanostructure for Water Purification. Phys. Status Solidi 2016, 253, 1480–1484. [Google Scholar] [CrossRef]
- Valbi, V.; Perez, A.; Verney-Carron, A.; Rossano, S. Impact of a Mn-Oxidizing Bacterial Strain on the Dissolution and Browning of a Mn-Bearing Potash-Lime Silicate Glass. Npj Mater. Degrad. 2023, 7, 20. [Google Scholar] [CrossRef]
- Postgate, J.R. Chapter XVIII Viable Counts and Viability. In Methods in Microbiology; Norris, J.R., Ribbons, D.W., Eds.; Academic Press: Cambridge, MA, USA, 1969; Volume 1, pp. 611–628. ISBN 0580-9517. [Google Scholar]
- Le Pivert, M.; Suo, H.; Tang, G.; Qiao, H.; Zhao, Z.; Martin, N.; Liu, C.; Leprince-Wang, Y. Improving Natural Sunlight Photocatalytic Efficiency of ZnO Nanowires Decorated by Iron Oxide Cocatalyst via a Simple Drop Method. Mater. Chem. Phys. 2022, 275, 125304. [Google Scholar] [CrossRef]
- Patil, A.; Dighavkar, C.; Sonawane, S.; Patil, S.; Borse, R. Effect of Firing Temperature on Electrical and Structural Characteristics of Screen Printed ZnO Thick Films. OAM-RC 2009, 3, 879–883. [Google Scholar]
- Pankove, J.I. Optical Processes in Semiconductors; Prentice-Hall: Englewood Cliffs, NJ, USA, 1979; ISBN 9780136380238, 0136380239. [Google Scholar]
- Tauc, J. Optical Properties and Electronic Structure of Amorphous Ge and Si. Mater. Res. Bull. 1968, 3, 37–46. [Google Scholar] [CrossRef]
- Çolak, H.; Karaköse, E.; Kartopu, G. Effect of Consumption of the Sol–Gel Deposited ZnO Seed Layer on the Growth and Properties of High Quality ZnO Nanorods. J. Mater. Sci. Mater. Electron. 2018, 29, 11964–11971. [Google Scholar] [CrossRef]
- Qi, K.; Xing, X.; Zada, A.; Li, M.; Wang, Q.; Liu, S.; Lin, H.; Wang, G. Transition Metal Doped ZnO Nanoparticles with Enhanced Photocatalytic and Antibacterial Performances: Experimental and DFT Studies. Ceram. Int. 2020, 46, 1494–1502. [Google Scholar] [CrossRef]
- Chitra, M.; Mangamma, G.; Uthayarani, K.; Neelakandeswari, N.; Girija, E.K. Band Gap Engineering in ZnO Based Nanocomposites. Phys. E Low-Dimens. Syst. Nanostructures 2020, 119, 113969. [Google Scholar] [CrossRef]
- Rai, R.C.; Guminiak, M.; Wilser, S.; Cai, B.; Nakarmi, M.L. Elevated Temperature Dependence of Energy Band Gap of ZnO Thin Films Grown by E-Beam Deposition. J. Appl. Phys. 2012, 111, 73511. [Google Scholar] [CrossRef]
- Wang, Y.; Yang, J.; Jia, H.; Yu, M.; Jin, H. Self-Assembled Urchin-like ZnO Nanostructures Fabricated by Electrodeposition-Hydrothermal Method. J. Alloys Compd. 2016, 665, 62–68. [Google Scholar] [CrossRef]
- Mcpeak, K.; Le, T.; Britton, N.; Nickolov, Z.; Elabd, Y.; Baxter, J. Chemical Bath Deposition of ZnO Nanowires at Near-Neutral PH Conditions without Hexamethylenetetramine (HMTA): Understanding the Role of HMTA in ZnO Nanowire Growth. Langmuir 2011, 27, 3672–3677. [Google Scholar] [CrossRef] [PubMed]
- Greene, L.E.; Yuhas, B.D.; Law, M.; Zitoun, D.; Yang, P. Solution-Grown Zinc Oxide Nanowires. Inorg. Chem. 2006, 45, 7535–7543. [Google Scholar] [CrossRef]
- Xie, W.; Li, Y.; Sun, W.; Huang, J.C.; Xie, H.; Zhao, X. Surface Modification of ZnO with Ag Improves Its Photocatalytic Efficiency and Photostability. J. Photochem. Photobiol. A-Chem. 2010, 216, 149–155. [Google Scholar] [CrossRef]
- Yang, L.-Y.; Dong, S.-Y.; Sun, J.-H.; Feng, J.-L.; Wu, Q.-H.; Sun, S.-P. Microwave-Assisted Preparation, Characterization and Photocatalytic Properties of a Dumbbell-Shaped ZnO Photocatalyst. J. Hazard. Mater. 2010, 179, 438–443. [Google Scholar] [CrossRef] [PubMed]
- Yang, C.; Li, Q.; Tang, L.; Xin, K.; Bai, A.; Yu, Y. Synthesis, Photocatalytic Activity, and Photogenerated Hydroxyl Radicals of Monodisperse Colloidal ZnO Nanospheres. Appl. Surf. Sci. 2015, 357, 1928–1938. [Google Scholar] [CrossRef]
- Fu, G.; Vary, P.S.; Lin, C.-T. Anatase TiO2 Nanocomposites for Antimicrobial Coatings. J. Phys. Chem. B 2005, 109, 8889–8898. [Google Scholar] [CrossRef]
- Edwards, J.V.A.; Edwards, K.J. Bacteria Cell. Available online: http://www.alken-murray.com/BioInfo1-05.html (accessed on 9 July 2010).
- Di, A.H.; Houghton Mifflin Company (Eds.) The American Heritage Medical Dictionary; Houghton Mifflin Company: Boston, MA, USA, 2007; ISBN 9780618824359. [Google Scholar]
- Wahab, R.; Kim, Y.-S.; Mishra, A.; Yun, S.-I.; Shin, H.-S. Formation of ZnO Micro-Flowers Prepared via Solution Process and Their Antibacterial Activity. Nanoscale Res. Lett. 2010, 5, 1675–1681. [Google Scholar] [CrossRef]
- Premanathan, M.; Karthikeyan, K.; Jeyasubramanian, K.; Manivannan, G. Selective Toxicity of ZnO Nanoparticles toward Gram-Positive Bacteria and Cancer Cells by Apoptosis through Lipid Peroxidation. Nanomedicine 2011, 7, 184–192. [Google Scholar] [CrossRef]
- Raghupathi, K.R.; Koodali, R.T.; Manna, A.C. Size-Dependent Bacterial Growth Inhibition and Mechanism of Antibacterial Activity of Zinc Oxide Nanoparticles. Langmuir 2011, 27, 4020–4028. [Google Scholar] [CrossRef]
- Yamamoto, O. Influence of Particle Size on the Antibacterial Activity of Zinc Oxide. Int. J. Inorg. Mater. 2001, 3, 643–646. [Google Scholar] [CrossRef]
- Wahab, R.; Mishra, A.; Yun, S.-I.; Kim, Y.-S.; Shin, H.-S. Antibacterial Activity of ZnO Nanoparticles Prepared via Non-Hydrolytic Solution Route. Appl. Microbiol. Biotechnol. 2010, 87, 1917–1925. [Google Scholar] [CrossRef] [PubMed]
- Stanković, A.; Dimitrijević, S.; Uskoković, D. Influence of Size Scale and Morphology on Antibacterial Properties of ZnO Powders Hydrothemally Synthesized Using Different Surface Stabilizing Agents. Colloids Surf. B. Biointerfaces 2013, 102, 21–28. [Google Scholar] [CrossRef] [PubMed]
- Padmavathy, N.; Vijayaraghavan, R. Enhanced Bioactivity of ZnO Nanoparticles-an Antimicrobial Study. Sci. Technol. Adv. Mater. 2008, 9, 35004. [Google Scholar] [CrossRef] [PubMed]
- Talebian, N.; Amininezhad, S.M.; Doudi, M. Controllable Synthesis of ZnO Nanoparticles and Their Morphology-Dependent Antibacterial and Optical Properties. J. Photochem. Photobiol. B Biol. 2013, 120, 66–73. [Google Scholar] [CrossRef] [PubMed]
- Ma, J.; Liu, J.; Bao, Y.; Zhu, Z.; Wang, X.; Zhang, J. Synthesis of Large-Scale Uniform Mulberry-like ZnO Particles with Microwave Hydrothermal Method and Its Antibacterial Property. Ceram. Int. 2013, 39, 2803–2810. [Google Scholar] [CrossRef]
- Ann, L.; Mahmud, S.; Mohd Bakhori, S.; Sirelkhatim, A.; Mohamad, D.; Hasan, H.; Seeni, A.; Rahman, R. Effect of Surface Modification and UVA Photoactivation on Antibacterial Bioactivity of Zinc Oxide Powder. Appl. Surf. Sci. 2014, 292, 405–412. [Google Scholar] [CrossRef]
- Mamat, M.H.; Khusaimi, Z.; Zahidi, M.M.; Mahmood, M.R. Performance of an Ultraviolet Photoconductive Sensor Using Well-Aligned Aluminium-Doped Zinc-Oxide Nanorod Arrays Annealed in an Air and Oxygen Environment. Jpn. J. Appl. Phys. 2011, 50, 06GF05. [Google Scholar] [CrossRef]
- Zhang, L.; Jiang, Y.; Ding, Y.; Povey, M.; York, D. Investigation into the Antibacterial Behaviour of Suspensions of ZnO Nanoparticles (ZnO Nanofluids). J. Nanoparticle Res. 2007, 9, 479–489. [Google Scholar] [CrossRef]
- Adams, L.K.; Lyon, D.Y.; Alvarez, P.J.J. Comparative Eco-Toxicity of Nanoscale TiO2, SiO2, and ZnO Water Suspensions. Water Res. 2006, 40, 3527–3532. [Google Scholar] [CrossRef]
- Kasemets, K.; Ivask, A.; Dubourguier, H.-C.; Kahru, A. Toxicity of Nanoparticles of ZnO, CuO and TiO2 to Yeast Saccharomyces Cerevisiae. Toxicol. Vitr. Int. J. Publ. Assoc. BIBRA 2009, 23, 1116–1122. [Google Scholar] [CrossRef] [PubMed]
- Li, M.; Zhu, L.; Lin, D. Toxicity of ZnO Nanoparticles to Escherichia Coli: Mechanism and the Influence of Medium Components. Environ. Sci. Technol. 2011, 45, 1977–1983. [Google Scholar] [CrossRef] [PubMed]
- Jalal, R.; Goharshadi, E.K.; Abareshi, M.; Moosavi, M.; Yousefi, A.; Nancarrow, P. ZnO Nanofluids: Green Synthesis, Characterization, and Antibacterial Activity. Mater. Chem. Phys. 2010, 121, 198–201. [Google Scholar] [CrossRef]
- Sawai, J.; Shoji, S.; Igarashi, H.; Hashimoto, A.; Kokugan, T.; Shimizu, M.; Kojima, H. Hydrogen Peroxide as an Antibacterial Factor in Zinc Oxide Powder Slurry. J. Ferment. Bioeng. 1998, 86, 521–522. [Google Scholar] [CrossRef]
- Zhang, L.; Ding, Y.; Povey, M.; York, D. ZnO Nanofluids—A Potential Antibacterial Agent. Prog. Nat. Sci. 2008, 18, 939–944. [Google Scholar] [CrossRef]
- Hirota, K.; Sugimoto, M.; Kato, M.; Tsukagoshi, K.; Tanigawa, T.; Sugimoto, H. Preparation of Zinc Oxide Ceramics with a Sustainable Antibacterial Activity under Dark Conditions. Ceram. Int. 2010, 36, 497–506. [Google Scholar] [CrossRef]
- Pasquet, J.; Chevalier, Y.; Pelletier, J.; Couval, E.; Bouvier, D.; Bolzinger, M.-A. The Contribution of Zinc Ions to the Antimicrobial Activity of Zinc Oxide. Colloids Surf. A Physicochem. Eng. Asp. 2014, 457, 263–274. [Google Scholar] [CrossRef]

| Product Name | Chemical Formula/ Composition | Supplier |
|---|---|---|
| Zinc acetate dihydrate | Zn(CH3COO)2∙2H2O | VWR Chemicals, Leuven, Belgium |
| Poly-vinyl alcohol (PVA) | (C2H4O)x | Merck KGaA, Darmstadt, Germany |
| Zinc nitrate hexahydrate | Zn(NO3)2∙6H2O | CARLO ERBA, Val de Reuil, France |
| Hexamethylenetetramine (HTMA) | (CH2)6N4 | Merck KGaA, Darmstadt, Germany |
| Methylthioninium chloride (Methylene Blue hydrate, MB) | C16H18ClN3S | Sigma Aldrich Chimie S.a.r.l, Saint-Quentin-Fallavier, France |
| Lysogeny Broth, Miller (LB-Miller) | NaCl, tryptone, and yeast extract | Sigma Aldrich Chimie S.a.r.l, Saint-Quentin-Fallavier, France |
| Lysogeny Broth with agar, Miller | Agar, NaCl, tryptone, and yeast extract | Sigma Aldrich Chimie S.a.r.l, Saint-Quentin-Fallavier, France |
| Sodium chloride | NaCl | VWR Chemicals, Leuven, Belgium |
| Ammonium chloride | NH4Cl | Thermo Scientific Chemicals, Geel, Belgium |
| di-sodium hydrogen phosphate anhydrous | Na2HPO4 | VWR Chemicals, Leuven, Belgium |
| D-Glucose (dextrose) anhydrous | C₆H₁₂O₆ | VWR Chemicals, Leuven, Belgium |
| 4-(2 hydroxyethyl)piperazin-1-ylethanesulphonic acid (HEPES) | C₈H₁₈N₂O₄S | VWR Chemicals, Leuven, Belgium |
| Culture Medium | Composition | Sample Name |
|---|---|---|
| Lysogeny Broth, Miller | NaCl, 10 g L−1 | M1 |
| Tryptone, 10 g L−1 | ||
| Yeast extract, 10 g L−1 | ||
| Modified culture solution | Glucose, 1 g L−1 | M2 |
| NH4Cl, 1 g L−1 | ||
| NaCl, 0.5 g L−1 | ||
| Na2HPO4, 6.06 g L−1 | ||
| HEPES buffer, 10 mM |
Disclaimer/Publisher’s Note: The statements, opinions and data contained in all publications are solely those of the individual author(s) and contributor(s) and not of MDPI and/or the editor(s). MDPI and/or the editor(s) disclaim responsibility for any injury to people or property resulting from any ideas, methods, instructions or products referred to in the content. |
© 2023 by the authors. Licensee MDPI, Basel, Switzerland. This article is an open access article distributed under the terms and conditions of the Creative Commons Attribution (CC BY) license (https://creativecommons.org/licenses/by/4.0/).
Share and Cite
Abou Zeid, S.; Perez, A.; Bastide, S.; Le Pivert, M.; Rossano, S.; Remita, H.; Hautière, N.; Leprince-Wang, Y. Antibacterial and Photocatalytic Properties of ZnO Nanostructure Decorated Coatings. Coatings 2024, 14, 41. https://doi.org/10.3390/coatings14010041
Abou Zeid S, Perez A, Bastide S, Le Pivert M, Rossano S, Remita H, Hautière N, Leprince-Wang Y. Antibacterial and Photocatalytic Properties of ZnO Nanostructure Decorated Coatings. Coatings. 2024; 14(1):41. https://doi.org/10.3390/coatings14010041
Chicago/Turabian StyleAbou Zeid, Souad, Anne Perez, Stéphane Bastide, Marie Le Pivert, Stéphanie Rossano, Hynd Remita, Nicolas Hautière, and Yamin Leprince-Wang. 2024. "Antibacterial and Photocatalytic Properties of ZnO Nanostructure Decorated Coatings" Coatings 14, no. 1: 41. https://doi.org/10.3390/coatings14010041
APA StyleAbou Zeid, S., Perez, A., Bastide, S., Le Pivert, M., Rossano, S., Remita, H., Hautière, N., & Leprince-Wang, Y. (2024). Antibacterial and Photocatalytic Properties of ZnO Nanostructure Decorated Coatings. Coatings, 14(1), 41. https://doi.org/10.3390/coatings14010041

